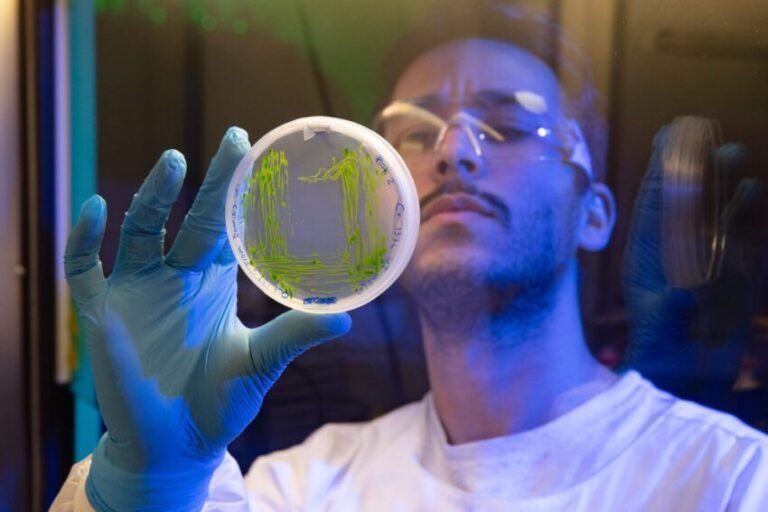

Provectus Algae is set to introduce a non-GMO, red and natural colorant for meat alternatives that changes color when cooked, as well as new ingredients for cosmetics market
Sugar-eating organisms such as yeast and bacteria dominate industrial fermentation today. According to Australian food and cosmetic ingredients startup Provectus Algae, organisms that consume more sustainable feedstocks will be the ‘predominant biomanufacturing platforms of tomorrow’.
Nusqe Spanton, the CEO and founder of Nusqe, has developed a “carbon negative” growth platform that he claims can unlock the potential of algae as a source of high-value ingredients. The innovative start-up advocating decarbonizing supply chain has just secured a strategic investment from CJ Bio, part of Korean biomanufacturing giant CJ CheilJedang.
Provectus Algae is set to introduce a non-GMO, red and natural colorant for meat alternatives that changes color when cooked, as well as new ingredients for cosmetics market from two demonstration plants in Australia.
“Our production technology allows us to deliver a more stable red color at a price over the next two years that will be able to compete with beetroot powder. We’re expecting regulatory approvals this year in Australia, New Zealand, the US and potentially moving forward into Singapore next year. And then we’ll look at the European market” he adds.
By contrast, yeast, fungi, and bacteria rely on sugar as a feedstock, an agricultural product with an environmental footprint that is also subject to pricing fluctuations that could make the economics of precision fermentation increasingly challenging.
“A 200,000-liter precision fermentation facility using Pichia [yeast] making 50 tons of product generates about 250-300 tons of carbon dioxide. Whereas our facilities are carbon negative. We pump air into our reactors and the microbes capture the carbon dioxide, convert it into carbon and release oxygen and clean water. We need lighting, but if facilities run on renewable energy, you’re looking at an extremely low cost of operating and a carbon negative positioning, which we must move towards if we want to decarbonize the supply chain. But yeast cells are not well equipped to produce some of the more complex molecules found in nature, which is prompting renewed interest in algae and plant cells, which have different internal machinery” adds Spanton.